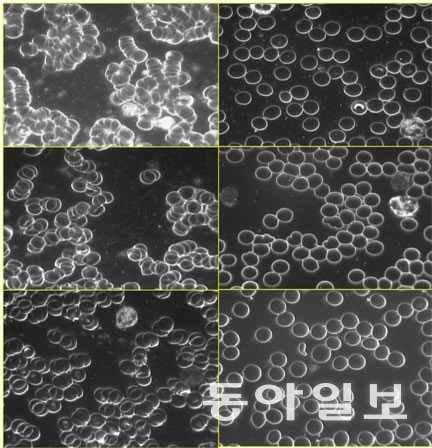

“맨발 걷기로 파킨슨병 호전, 치매 예방에도 도움이 됩니다”[양종구의 100세 시대 건강법]
인천=양종구기자
입력 2023-08-12 12:00 수정 2023-08-12 12:18
한의사인 이강일 나사렛국제병원 이사장(80)은 7년 전 파킨슨병에 걸려 고생했다. 그는 “누웠다 앉는 게 힘들었다. 걷는 데도 어려움이 많았다”고 했다.
 이강일 이사장이 인천 연수구 청량산에 올라 맨발로 황톳길을 걷고 있다. 맨발걷기국민운동분부 인천연수구지회 제공.
이강일 이사장이 인천 연수구 청량산에 올라 맨발로 황톳길을 걷고 있다. 맨발걷기국민운동분부 인천연수구지회 제공.
파킨슨병은 뇌의 신경전달물질인 도파민을 분비하는 세포들이 파괴되면서 나타나는 중추신경계 질환이다. 도파민은 운동 능력이나 감정 등을 조절하는 역할을 해 분비가 감소하면 무기력, 우울감 등이 나타날 수 있다. 또한 손발의 떨림, 몸의 경직, 불안정한 걸음걸이나 자세, 느린 동작 등과 같은 운동 능력 저하 증상이 따르게 된다.
이 이사장은 지난해 9월쯤 지인으로부터 “맨발로 맨땅을 걸으면 건강이 좋아진다”고 들은 뒤 원리를 공부한 뒤 맨발 걷기를 시작했다. 지금은 누웠다 일어나는 것, 걷는 데도 큰 문제 없는 상태가 됐다. 정형외과 전문의 등 의사들은 “80세 노인이 파킨슨병에서 호전되기는 쉽지 않은 일”이라고 보고 있다.
이 이사장은 “지인의 말을 들은 뒤 박동창 맨발걷기국민운동본부 회장(71)이 쓴 ‘맨발로 걸어라’란 책을 봤다. 일리가 있는 얘기라고 생각해 걷기 시작했다”고 했다. 박 회장은 맨발 걷기로 건강이 좋아진 뒤 그 효과를 홍보하고 있다. ‘맨발로 걷는 즐거움’ ‘맨발로 걸어라’ ‘맨발 걷기의 첫 걸음’ ‘맨발 걷기가 나를 살렸다’ 등 책도 썼다. 2016년부터 서울 대모산에서 맨발걷기숲길힐링캠프를 운영하고 있는 박 회장은 “맨발로 걸으면 지압효과와 접지효과(Earthing)로 면역력이 좋아진다”고 주장하고 있다.
 이강일 이사장(앞)이 인천 연수구 청량산에 올라 맨발로 걷고 있다. 맨발걷기국민운동분부 인천연수구지회 제공.
이강일 이사장(앞)이 인천 연수구 청량산에 올라 맨발로 걷고 있다. 맨발걷기국민운동분부 인천연수구지회 제공.
이 이사장은 병원 근처인 인천 연수구 청량산의 황톳길을 매일 걷는다. 처음엔 제대로 걷지도 못해 양쪽에 목발을 짚고, 다른 사람의 도움을 받아서 걸었다. 지난 11개월간 하루도 빼지 않고 매일 2시간 30분 이상을 걸었다. 지금은 안전을 위해 지팡이 하나 들고 걷고 있다.
“도파민을 먹다 보면 변비가 생겨요. 그래서 증상이 심할 때 도파민 복용량을 늘려야 하는데 그러지 못하고 있었죠. 그런데 맨발로 한 달 정도 걸으니 변비가 없어진 겁니다. 잠도 잘 왔어요. 전 스트레스 받으면 잠을 푹 못 잤는데 맨발로 걸은 뒤엔 잠도 쉽게 들고 깨지 않고 끝까지 잘 잤어요. 다리 부종과 이명증도 사라졌어요. 다리가 자주 부어 신장 기능에 이상이 있는 것으로 봤는데 그게 호전된 것 같습니다. 그 외에도 제가 알 수 없는 몸에 있는 문제점들도 해결된 것 같습니다. 물론 걷는 것도 편안해졌고. 손도 일절 떨지 않아요. 아직 약간 불편하긴 한데 누웠다 일어나는 것, 걷는 게 아주 좋아졌어요. 완전히 좋아지기까지는 시간이 더 걸려야겠지만 맨발걷기로 새로운 삶을 살고 있습니다.”
이후 이 이사장은 하루에 도파민 한 알만 정기적으로 복용하고 있다. 그래도 파킨슨병 증세가 호전되고 있기 때문이다. 이 이사장은 맨발 걷기를 환자들에게도 적극 권유하고 있다.
 이강일 이사장이 환자에게 침을 놓고 있다. 인천=양종구 기자 yjongk@donga.com
이강일 이사장이 환자에게 침을 놓고 있다. 인천=양종구 기자 yjongk@donga.com
이 이사장은 50년 전 한의원을 시작해 일찌감치 600병상 ‘양한방협진’ 병원으로 발전시켜 오늘에 이르고 있다. 그는 “사람을 치료하는데 양의학과 한의학이 따로 없다. 병을 고치는데 도움이 된다면 활용해야 한다”고 강조했다. 그는 “자연과 가까이 하면 자연이 치료해주는 것이라고 생각한다”고 했다. 그는 “민간요법이든 자연요법이든 경험을 해본 사람들이 늘어나면서 자꾸 얘기해줘서 그 경험을 함께 나누다 보면 저절로 좋아지는 것”이라고 말했다. 이 이사장은 “맨발 걷기를 하면서 햇볕, 공기, 땅 등 우리가 접촉하는 모든 자연이 몸의 면역력을 증강 시킨다는 생각을 했다”고 말했다. 그는 “면역력이 좋아지니 기억력도 좋아졌다. 과거 생각나지 않던 초중고교 동창 친구들의 이름이 떠오르기 시작했다. 아주 오래전에 잊어버린 이름들이었다”고 했다.
이 이사장은 맨발 걷기를 치료에 활용하는 계획까지 밝혔다. 그는 “인천 남동구 논현동에 5800평(약 1만9200㎡) 부지를 마련해 일반치료와 함께 맨발 걷기도 병행할 수 있는 한방요양병원을 건설한다”고 했다. 병원 부지 산에 맨발 걷기 길을 조성해 활용하겠다는 뜻이다. 조만간 착공에 들어가 2025년 개원할 예정이다. 그는 “양의학적 치료는 현재 나사렛국제병원에서 계속하고, 한방요양병원에서는 한의학과 자연요법 치료에 집중할 것”이라고 했다.
 이강일 이사장이 병원에서 호전된 환자의 사례를 설명하고 있다. 인천=양종구 기자 yjongk@donga.com
이강일 이사장이 병원에서 호전된 환자의 사례를 설명하고 있다. 인천=양종구 기자 yjongk@donga.com
이 이사장은 파킨슨병이 걸린 뒤 움직이는데 불편함이 있었지만 환자 진료는 계속해왔다. 맨발 걷기로 몸이 좋아진 뒤에는 오전 진료만 한다. 오후엔 맨발로 걸어야 하기 때문이다. 이 이사장은 매일 오후 2시간 30분 이상을 맨발로 맨땅을 걷고 있다. 인천 청량산은 어느 정도 올라가면 황금색을 띨 정도로 좋은 자연 황톳길이 조성돼 있었다. 흙 중엔 황톳길이 맨발 걷기 효과를 가장 잘 볼 수 있는 곳이다.
이 이사장은 맨발 걷기가 노인성 질환인 파킨슨병, 알츠하이머(치매), 뇌졸중 등의 예방에도 도움이 된다는 의견이다. “이 질병들은 뇌신경 및 혈관에 이상이 있어 온다는 점에서 유사하죠. 그래서 맨발 걷기가 도움이 된다고 봅니다. 치매도 호전될 수는 있는데 치매 환자의 의지가 발현되기 쉽지 않아 예방을 위해 맨발 걷기를 해야 합니다. 파킨슨병과 치매, 뇌졸중 예방엔 큰 도움이 됩니다. 중요한 것은 믿는 것입니다. 저를 보십시오. 믿고 따라 해서 파킨슨병도 호전됐습니다. 특히 치매는 치료보다 예방이 중요합니다.”
 이강일 이사장(왼쪽)과 박동창 회장이 인천 연수구 청량산에서 맨발로 포즈를 취했다. 맨발걷기국민운동분부 인천연수구지회 제공.박 회장은 맨발 걷기로 여러 효과를 얻을 수 있다고 말한다. 맨발로 맨땅을 걸으면 지표면에 놓여 있는 돌멩이나 나무뿌리, 나뭇가지 등 다양한 물질이 발바닥의 각 부위와 상호마찰하고, 땅과 그 위에 놓인 각종 물질이 발바닥의 각 반사구를 눌러준다. 발바닥 자극은 오장육부 등 모든 신체기관에 긍정적인 영향을 미친다는 연구 결과가 고대 중국과 이집트에서부터 이어졌다.
이강일 이사장(왼쪽)과 박동창 회장이 인천 연수구 청량산에서 맨발로 포즈를 취했다. 맨발걷기국민운동분부 인천연수구지회 제공.박 회장은 맨발 걷기로 여러 효과를 얻을 수 있다고 말한다. 맨발로 맨땅을 걸으면 지표면에 놓여 있는 돌멩이나 나무뿌리, 나뭇가지 등 다양한 물질이 발바닥의 각 부위와 상호마찰하고, 땅과 그 위에 놓인 각종 물질이 발바닥의 각 반사구를 눌러준다. 발바닥 자극은 오장육부 등 모든 신체기관에 긍정적인 영향을 미친다는 연구 결과가 고대 중국과 이집트에서부터 이어졌다.
접지는 맨발로 땅을 밟는 행위다. 시멘트 아스팔트 등은 효과가 없다. 황톳길이 가장 좋다. 우리 몸에 30~60 밀리볼트의 양전하가 흐르는데 맨발로 땅을 만나는 순간 0볼트가 된다고 한다. 땅의 음전하와 만나 중화되는데 이때 우리 몸에 쌓인 활성산소가 빠져나간다는 것이다. 박 회장은 “원래 활성산소는 몸의 곪거나 상처 난 곳을 치유하라고 몸 자체에서 보내는 방위군이다. 치유하고 나면 활성산소는 몸 밖으로 배출돼야 하는데 그러지를 못하고 몸속을 돌아다니면서 멀쩡한 세포를 공격해 악성 세포로 바뀌게 한다. 암 등 각종 질병이 활성산소의 역기능 탓에 발생하는 것”이라고 설명했다. 맨발 걷기를 하면 활성산소가 배출되고 면역력이 좋아진다는 것이다.
박 회장은 이 이사장의 사례에 대해 “맨발 걷기로 혈액이 뇌에 공급돼 뇌세포를 살려낸 결과”라고 설명했다. 2013년 미국 ‘대체 및 보완의학학회지’에 발표된 ‘접지는 혈액의 점성을 낮춰준다(스티븐 시나트라 등)’는 논문에 따르면 끈적끈적한 점성이 있는 혈액이 맨발 걷기 40분 뒤 깨끗해졌다. 또한 적혈구 제타전위(Zeta Potential·표면 세포간 밀어내는 힘)를 평균 2.7배 높여줘 혈류 속도가 2.7배로 빨라졌다. 박 회장은 이를 ‘천연의 혈액희석효과’로 불렀다. 박 회장은 “맨발 걷기는 우리 몸의 중요한 에너지인 ATP(아데노신삼인산)생성에도 큰 도움이 된다. 맨발 걷기는 스트레스 받으면 올라가는 호르몬 코르티솔 분비도 안정시켜준다”고 말했다.
▶관련 동영상 보기 :
 맨발걷기 전(왼쪽)과 맨발걷기 40분 후(오른쪽) 혈액. 2013년 미국 ‘대체 및 보완의학학회지’에 발표된 ‘접지는 혈액의 점성을 낮춰준다(스티븐 시나트라 등)’는 논문에 따르면 끈적끈적한 점성이 있는 혈액이 맨발걷기 40분 뒤 깨끗해졌다. 또한 적혈구 제타전위(Zeta Potential·표면 세포간 밀어내는 힘)를 평균 2.7배 높여줘 혈류 속도가 2.7배로 빨라졌다. 박동창 맨발걷기시민운동본부 회장은 이를 ‘천연의 혈액희석효과‘라고 불렀다. 박동창 회장 제공.맨발 걷기가 두뇌 발달에도 도움이 된다는 의견도 있다. 박 회장은 “혈액 순환이 잘 돼 머리가 깨끗해진다. 일본에 있는 토리야마유치원의 경우 3살부터 6살까지 맨발로 뛰고 걷게 하는데 집중력이 엄청 좋아진다는 결과가 나왔다. 아이들이 3년 동안 책을 2000권 씩 읽는다. 생각이 긍정적으로 바뀌고 자신감도 상승한다”고 설명했다.
맨발걷기 전(왼쪽)과 맨발걷기 40분 후(오른쪽) 혈액. 2013년 미국 ‘대체 및 보완의학학회지’에 발표된 ‘접지는 혈액의 점성을 낮춰준다(스티븐 시나트라 등)’는 논문에 따르면 끈적끈적한 점성이 있는 혈액이 맨발걷기 40분 뒤 깨끗해졌다. 또한 적혈구 제타전위(Zeta Potential·표면 세포간 밀어내는 힘)를 평균 2.7배 높여줘 혈류 속도가 2.7배로 빨라졌다. 박동창 맨발걷기시민운동본부 회장은 이를 ‘천연의 혈액희석효과‘라고 불렀다. 박동창 회장 제공.맨발 걷기가 두뇌 발달에도 도움이 된다는 의견도 있다. 박 회장은 “혈액 순환이 잘 돼 머리가 깨끗해진다. 일본에 있는 토리야마유치원의 경우 3살부터 6살까지 맨발로 뛰고 걷게 하는데 집중력이 엄청 좋아진다는 결과가 나왔다. 아이들이 3년 동안 책을 2000권 씩 읽는다. 생각이 긍정적으로 바뀌고 자신감도 상승한다”고 설명했다.
‘100세 시대 건강법’ 시리즈를 통해 2020년 9월 박 회장의 사연이 전해진 뒤 맨발 걷기가 널리 알려지기 시작했다. 지난해 9월 소개된 전립선암 말기 환자였던 박성태 씨(74)도 맨발 걷기를 통해 건강을 많이 회복했다. 의학적으로 100% 증명되지 않았다는 주장이 있지만 최근 맨발 걷기로 건강을 되찾은 사례를 어렵지 않게 찾아볼 수 있다. 지상파 방송 다큐멘터리에서도 맨발 걷기를 통한 긍정적인 신체 변화를 자세히 소개하기도 했다.
 이강일 이사장과 박동창 회장(가운데)이 인천 연수구 청량산에 올라 함께 맨발로 걸은 시민들과 포즈를 취했다. 맨발걷기국민운동분부 인천연수구지회 제공.
이강일 이사장과 박동창 회장(가운데)이 인천 연수구 청량산에 올라 함께 맨발로 걸은 시민들과 포즈를 취했다. 맨발걷기국민운동분부 인천연수구지회 제공.
사실 이 이사장은 맨발걷기로 파킨슨병 증세가 호전됐다는 얘기를 공개적으로 하기 쉽지 않았다. 한의사기 때문이다. 의학계에선 아직도 부정적인 시각으로 보고 있다. 주위에서도 말렸다. 하지만 그는 “내가 효과를 봤는데 다른 사람에게도 도움이 되게 만들어야 하지 않느냐. 난 사람을 고치는 의사”라며 사연을 공개했다.
인천=양종구기자 yjongk@donga.com
 이강일 이사장이 인천 연수구 청량산에 올라 맨발로 황톳길을 걷고 있다. 맨발걷기국민운동분부 인천연수구지회 제공.
이강일 이사장이 인천 연수구 청량산에 올라 맨발로 황톳길을 걷고 있다. 맨발걷기국민운동분부 인천연수구지회 제공.파킨슨병은 뇌의 신경전달물질인 도파민을 분비하는 세포들이 파괴되면서 나타나는 중추신경계 질환이다. 도파민은 운동 능력이나 감정 등을 조절하는 역할을 해 분비가 감소하면 무기력, 우울감 등이 나타날 수 있다. 또한 손발의 떨림, 몸의 경직, 불안정한 걸음걸이나 자세, 느린 동작 등과 같은 운동 능력 저하 증상이 따르게 된다.
이 이사장은 지난해 9월쯤 지인으로부터 “맨발로 맨땅을 걸으면 건강이 좋아진다”고 들은 뒤 원리를 공부한 뒤 맨발 걷기를 시작했다. 지금은 누웠다 일어나는 것, 걷는 데도 큰 문제 없는 상태가 됐다. 정형외과 전문의 등 의사들은 “80세 노인이 파킨슨병에서 호전되기는 쉽지 않은 일”이라고 보고 있다.
이 이사장은 “지인의 말을 들은 뒤 박동창 맨발걷기국민운동본부 회장(71)이 쓴 ‘맨발로 걸어라’란 책을 봤다. 일리가 있는 얘기라고 생각해 걷기 시작했다”고 했다. 박 회장은 맨발 걷기로 건강이 좋아진 뒤 그 효과를 홍보하고 있다. ‘맨발로 걷는 즐거움’ ‘맨발로 걸어라’ ‘맨발 걷기의 첫 걸음’ ‘맨발 걷기가 나를 살렸다’ 등 책도 썼다. 2016년부터 서울 대모산에서 맨발걷기숲길힐링캠프를 운영하고 있는 박 회장은 “맨발로 걸으면 지압효과와 접지효과(Earthing)로 면역력이 좋아진다”고 주장하고 있다.
 이강일 이사장(앞)이 인천 연수구 청량산에 올라 맨발로 걷고 있다. 맨발걷기국민운동분부 인천연수구지회 제공.
이강일 이사장(앞)이 인천 연수구 청량산에 올라 맨발로 걷고 있다. 맨발걷기국민운동분부 인천연수구지회 제공.이 이사장은 병원 근처인 인천 연수구 청량산의 황톳길을 매일 걷는다. 처음엔 제대로 걷지도 못해 양쪽에 목발을 짚고, 다른 사람의 도움을 받아서 걸었다. 지난 11개월간 하루도 빼지 않고 매일 2시간 30분 이상을 걸었다. 지금은 안전을 위해 지팡이 하나 들고 걷고 있다.
“도파민을 먹다 보면 변비가 생겨요. 그래서 증상이 심할 때 도파민 복용량을 늘려야 하는데 그러지 못하고 있었죠. 그런데 맨발로 한 달 정도 걸으니 변비가 없어진 겁니다. 잠도 잘 왔어요. 전 스트레스 받으면 잠을 푹 못 잤는데 맨발로 걸은 뒤엔 잠도 쉽게 들고 깨지 않고 끝까지 잘 잤어요. 다리 부종과 이명증도 사라졌어요. 다리가 자주 부어 신장 기능에 이상이 있는 것으로 봤는데 그게 호전된 것 같습니다. 그 외에도 제가 알 수 없는 몸에 있는 문제점들도 해결된 것 같습니다. 물론 걷는 것도 편안해졌고. 손도 일절 떨지 않아요. 아직 약간 불편하긴 한데 누웠다 일어나는 것, 걷는 게 아주 좋아졌어요. 완전히 좋아지기까지는 시간이 더 걸려야겠지만 맨발걷기로 새로운 삶을 살고 있습니다.”
이후 이 이사장은 하루에 도파민 한 알만 정기적으로 복용하고 있다. 그래도 파킨슨병 증세가 호전되고 있기 때문이다. 이 이사장은 맨발 걷기를 환자들에게도 적극 권유하고 있다.
살아가면서 수많은 질병을 접하고 걸리게 됩니다. 갑자기 오는 경우도 있죠. 특히 나이 든 분들에게는 언제 어떤 병이 찾아올지 모릅니다. 현대엔 질병을 예방하는 의학이 있고 치료하는 의학이 있죠. 크게 양의학과 한의학으로 나뉘어 있지만 우리가 굳이 민간 치료요법과 자연치료요법을 경시할 필요는 없어요. 현대의학인 양의학, 한의학으로 병을 예방하고 치료하면서도 민간요법과 자연요법도 병행할 수 있다고 생각합니다. 현대의학도 중요하지만 민간요법과 자연요법은 경험에 의해서 많은 사람들이 질병에서 벗어났다는 것을 감각적으로 느끼는 겁니다. 전 그렇게 생각합니다. 모든 질병을 현대의학으로 다 해결할 수 있는 것이 아니라면 다양한 시도를 해봐야 합니다. 민간요법은 경험의 산물이고, 자연요법은 자연의 섭리를 이용한 것이기 때문입니다.”
 이강일 이사장이 환자에게 침을 놓고 있다. 인천=양종구 기자 yjongk@donga.com
이강일 이사장이 환자에게 침을 놓고 있다. 인천=양종구 기자 yjongk@donga.com이 이사장은 50년 전 한의원을 시작해 일찌감치 600병상 ‘양한방협진’ 병원으로 발전시켜 오늘에 이르고 있다. 그는 “사람을 치료하는데 양의학과 한의학이 따로 없다. 병을 고치는데 도움이 된다면 활용해야 한다”고 강조했다. 그는 “자연과 가까이 하면 자연이 치료해주는 것이라고 생각한다”고 했다. 그는 “민간요법이든 자연요법이든 경험을 해본 사람들이 늘어나면서 자꾸 얘기해줘서 그 경험을 함께 나누다 보면 저절로 좋아지는 것”이라고 말했다. 이 이사장은 “맨발 걷기를 하면서 햇볕, 공기, 땅 등 우리가 접촉하는 모든 자연이 몸의 면역력을 증강 시킨다는 생각을 했다”고 말했다. 그는 “면역력이 좋아지니 기억력도 좋아졌다. 과거 생각나지 않던 초중고교 동창 친구들의 이름이 떠오르기 시작했다. 아주 오래전에 잊어버린 이름들이었다”고 했다.
이 이사장은 맨발 걷기를 치료에 활용하는 계획까지 밝혔다. 그는 “인천 남동구 논현동에 5800평(약 1만9200㎡) 부지를 마련해 일반치료와 함께 맨발 걷기도 병행할 수 있는 한방요양병원을 건설한다”고 했다. 병원 부지 산에 맨발 걷기 길을 조성해 활용하겠다는 뜻이다. 조만간 착공에 들어가 2025년 개원할 예정이다. 그는 “양의학적 치료는 현재 나사렛국제병원에서 계속하고, 한방요양병원에서는 한의학과 자연요법 치료에 집중할 것”이라고 했다.
 이강일 이사장이 병원에서 호전된 환자의 사례를 설명하고 있다. 인천=양종구 기자 yjongk@donga.com
이강일 이사장이 병원에서 호전된 환자의 사례를 설명하고 있다. 인천=양종구 기자 yjongk@donga.com이 이사장은 파킨슨병이 걸린 뒤 움직이는데 불편함이 있었지만 환자 진료는 계속해왔다. 맨발 걷기로 몸이 좋아진 뒤에는 오전 진료만 한다. 오후엔 맨발로 걸어야 하기 때문이다. 이 이사장은 매일 오후 2시간 30분 이상을 맨발로 맨땅을 걷고 있다. 인천 청량산은 어느 정도 올라가면 황금색을 띨 정도로 좋은 자연 황톳길이 조성돼 있었다. 흙 중엔 황톳길이 맨발 걷기 효과를 가장 잘 볼 수 있는 곳이다.
이 이사장은 맨발 걷기가 노인성 질환인 파킨슨병, 알츠하이머(치매), 뇌졸중 등의 예방에도 도움이 된다는 의견이다. “이 질병들은 뇌신경 및 혈관에 이상이 있어 온다는 점에서 유사하죠. 그래서 맨발 걷기가 도움이 된다고 봅니다. 치매도 호전될 수는 있는데 치매 환자의 의지가 발현되기 쉽지 않아 예방을 위해 맨발 걷기를 해야 합니다. 파킨슨병과 치매, 뇌졸중 예방엔 큰 도움이 됩니다. 중요한 것은 믿는 것입니다. 저를 보십시오. 믿고 따라 해서 파킨슨병도 호전됐습니다. 특히 치매는 치료보다 예방이 중요합니다.”
 이강일 이사장(왼쪽)과 박동창 회장이 인천 연수구 청량산에서 맨발로 포즈를 취했다. 맨발걷기국민운동분부 인천연수구지회 제공.
이강일 이사장(왼쪽)과 박동창 회장이 인천 연수구 청량산에서 맨발로 포즈를 취했다. 맨발걷기국민운동분부 인천연수구지회 제공.접지는 맨발로 땅을 밟는 행위다. 시멘트 아스팔트 등은 효과가 없다. 황톳길이 가장 좋다. 우리 몸에 30~60 밀리볼트의 양전하가 흐르는데 맨발로 땅을 만나는 순간 0볼트가 된다고 한다. 땅의 음전하와 만나 중화되는데 이때 우리 몸에 쌓인 활성산소가 빠져나간다는 것이다. 박 회장은 “원래 활성산소는 몸의 곪거나 상처 난 곳을 치유하라고 몸 자체에서 보내는 방위군이다. 치유하고 나면 활성산소는 몸 밖으로 배출돼야 하는데 그러지를 못하고 몸속을 돌아다니면서 멀쩡한 세포를 공격해 악성 세포로 바뀌게 한다. 암 등 각종 질병이 활성산소의 역기능 탓에 발생하는 것”이라고 설명했다. 맨발 걷기를 하면 활성산소가 배출되고 면역력이 좋아진다는 것이다.
박 회장은 이 이사장의 사례에 대해 “맨발 걷기로 혈액이 뇌에 공급돼 뇌세포를 살려낸 결과”라고 설명했다. 2013년 미국 ‘대체 및 보완의학학회지’에 발표된 ‘접지는 혈액의 점성을 낮춰준다(스티븐 시나트라 등)’는 논문에 따르면 끈적끈적한 점성이 있는 혈액이 맨발 걷기 40분 뒤 깨끗해졌다. 또한 적혈구 제타전위(Zeta Potential·표면 세포간 밀어내는 힘)를 평균 2.7배 높여줘 혈류 속도가 2.7배로 빨라졌다. 박 회장은 이를 ‘천연의 혈액희석효과’로 불렀다. 박 회장은 “맨발 걷기는 우리 몸의 중요한 에너지인 ATP(아데노신삼인산)생성에도 큰 도움이 된다. 맨발 걷기는 스트레스 받으면 올라가는 호르몬 코르티솔 분비도 안정시켜준다”고 말했다.
▶관련 동영상 보기 :
맨발걷기 전(왼쪽)과 맨발걷기 40분 후(오른쪽) 혈액. 2013년 미국 ‘대체 및 보완의학학회지’에 발표된 ‘접지는 혈액의 점성을 낮춰준다(스티븐 시나트라 등)’는 논문에 따르면 끈적끈적한 점성이 있는 혈액이 맨발걷기 40분 뒤 깨끗해졌다. 또한 적혈구 제타전위(Zeta Potential·표면 세포간 밀어내는 힘)를 평균 2.7배 높여줘 혈류 속도가 2.7배로 빨라졌다. 박동창 맨발걷기시민운동본부 회장은 이를 ‘천연의 혈액희석효과‘라고 불렀다. 박동창 회장 제공.
맨발걷기 전(왼쪽)과 맨발걷기 40분 후(오른쪽) 혈액. 2013년 미국 ‘대체 및 보완의학학회지’에 발표된 ‘접지는 혈액의 점성을 낮춰준다(스티븐 시나트라 등)’는 논문에 따르면 끈적끈적한 점성이 있는 혈액이 맨발걷기 40분 뒤 깨끗해졌다. 또한 적혈구 제타전위(Zeta Potential·표면 세포간 밀어내는 힘)를 평균 2.7배 높여줘 혈류 속도가 2.7배로 빨라졌다. 박동창 맨발걷기시민운동본부 회장은 이를 ‘천연의 혈액희석효과‘라고 불렀다. 박동창 회장 제공.‘100세 시대 건강법’ 시리즈를 통해 2020년 9월 박 회장의 사연이 전해진 뒤 맨발 걷기가 널리 알려지기 시작했다. 지난해 9월 소개된 전립선암 말기 환자였던 박성태 씨(74)도 맨발 걷기를 통해 건강을 많이 회복했다. 의학적으로 100% 증명되지 않았다는 주장이 있지만 최근 맨발 걷기로 건강을 되찾은 사례를 어렵지 않게 찾아볼 수 있다. 지상파 방송 다큐멘터리에서도 맨발 걷기를 통한 긍정적인 신체 변화를 자세히 소개하기도 했다.
 이강일 이사장과 박동창 회장(가운데)이 인천 연수구 청량산에 올라 함께 맨발로 걸은 시민들과 포즈를 취했다. 맨발걷기국민운동분부 인천연수구지회 제공.
이강일 이사장과 박동창 회장(가운데)이 인천 연수구 청량산에 올라 함께 맨발로 걸은 시민들과 포즈를 취했다. 맨발걷기국민운동분부 인천연수구지회 제공.사실 이 이사장은 맨발걷기로 파킨슨병 증세가 호전됐다는 얘기를 공개적으로 하기 쉽지 않았다. 한의사기 때문이다. 의학계에선 아직도 부정적인 시각으로 보고 있다. 주위에서도 말렸다. 하지만 그는 “내가 효과를 봤는데 다른 사람에게도 도움이 되게 만들어야 하지 않느냐. 난 사람을 고치는 의사”라며 사연을 공개했다.
인천=양종구기자 yjongk@donga.com
비즈N 탑기사
 ‘책 출간’ 한동훈, 정계 복귀 움직임에 테마株 강세
‘책 출간’ 한동훈, 정계 복귀 움직임에 테마株 강세 조선 후기 화가 신명연 ‘화훼도 병풍’ 기념우표 발행
조선 후기 화가 신명연 ‘화훼도 병풍’ 기념우표 발행 붕괴 교량과 동일·유사 공법 3곳 공사 전면 중지
붕괴 교량과 동일·유사 공법 3곳 공사 전면 중지 명동 ‘위조 명품’ 판매 일당 덜미…SNS로 관광객 속였다
명동 ‘위조 명품’ 판매 일당 덜미…SNS로 관광객 속였다 “나대는 것 같아 안올렸는데”…기안84 ‘100 챌린지’ 뭐길래
“나대는 것 같아 안올렸는데”…기안84 ‘100 챌린지’ 뭐길래- ‘전참시’ 이연희, 득녀 5개월만 복귀 일상…아침 산책+운동 루틴
- 국내 기술로 개발한 ‘한국형 잠수함’ 기념우표 발행
- ‘아파트 지하주차장서 음주운전’ 인천시의원 송치
- 학령인구 감소 탓에 도심지 초교마저 학급 편성 ‘비상’
- 상속인 행세하며 100억 원 갈취한 사기꾼 일당 붙잡혀
 “과자에 반도체 입혔더니”…‘SK하이닉스 과자’ 20만개 팔렸다
“과자에 반도체 입혔더니”…‘SK하이닉스 과자’ 20만개 팔렸다 오늘부터 휴대폰 개통에 ‘안면인증’ 시범도입…“대포폰 차단”
오늘부터 휴대폰 개통에 ‘안면인증’ 시범도입…“대포폰 차단” 수출 사상 첫 7000억 달러 눈앞… 반도체 고군분투
수출 사상 첫 7000억 달러 눈앞… 반도체 고군분투 서울 서북권 관문 상암·수색의 변화…‘직주락 미래도시’ 변신
서울 서북권 관문 상암·수색의 변화…‘직주락 미래도시’ 변신 삼성전자-SK “미국산 AI 수출 프로그램 동참할 것”
삼성전자-SK “미국산 AI 수출 프로그램 동참할 것”- 국세청, 쿠팡 美본사 거래내역도 뒤진다… 전방위 세무조사
- 다이어트 콜라의 역습?…“아스파탐, 심장·뇌 손상 위험” 경고
- 12월 1~20일 수출 430억달러 6.8% 증가…반도체 41.8%↑
- 23일부터 폰 개통에 안면인증…내년 3월부터 정식 도입
- 서울 아파트 월세, 올 3% 넘게 올라… 송파-용산은 6% 훌쩍
















![[시승기] 제주에서 느끼는 드라이빙의 즐거움…‘포르쉐 올레 드라이브’ [시승기] 제주에서 느끼는 드라이빙의 즐거움…‘포르쉐 올레 드라이브’](https://dimg.donga.com/wps/ECONOMY/FEED/BIZN_FEED_EVLOUNGE/132703912.2.thumb.jpg)